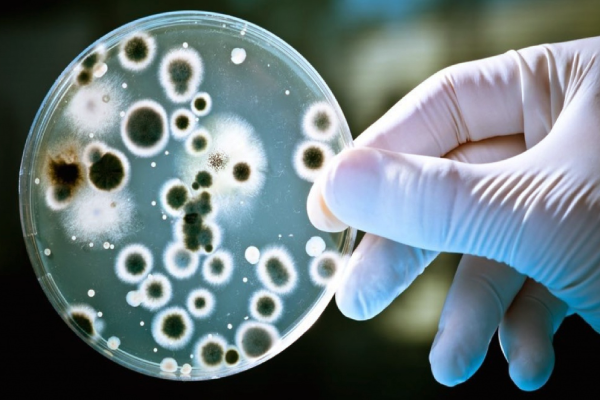
உண்மையில் வாழை இலையில் சாப்பிட காரணம் என்ன? அவசியம் தெரிஞ்சுக்கோங்க | Benefits Of Eating Food On Banana Leaf உண்மையில் வாழை இலையில் சாப்பிட காரணம் என்ன? அவசியம் தெரிஞ்சுக்கோங்க | Benefits Of Eating Food On Banana Leaf

உண்மையில் வாழை இலையில் சாப்பிட காரணம் என்ன? அவசியம் தெரிஞ்சுக்கோங்க
நமது முன்னோர் காலத்தில் இருந்து வாழை இலையில் சாப்பிடுவதை பழக்கப்படுத்தி வைத்துள்ளனர். முன்னோர்கள் ஏதாவது ஒன்றை நமக்கு விட்டு சென்றால் அதற்கு காரணம் இருக்கும் அந்த காரணத்தை பார்க்கலாம்.
வாழை இலையில் சாப்பிட காரணம் என்ன?
பெரும்பாலான வீடுகள் மற்றும் உணவகங்களில்,பிளாஸ்டிக் அல்லது பீங்கான் பாத்திரங்கள் சாப்பிடுவதற்குப் பயன்படுத்தப்படுகின்றன.
ஆனால் தென்னிந்தியாவில் பெரும்பாலான இடங்களில் வாழை இலைகளில் உணவு பரிமாறப்படுகிறது. இந்த நடைமுறை பழமையானது மற்றும் இது தற்போது பரவலாக நடைமுறையில் உள்ளது.
மேலும், வாழை இலைகளில் சாப்பிடுவது ஏராளமான ஆரோக்கிய நன்மைகளை தருகிறதாம். இதனாலேயே பல இடங்களில் சமைக்க, பரிமாற மற்றும் பேக்கேஜிங் செய்ய பயன்படுத்தப்படுகின்றன.

நன்மைகள்
ஊட்டச்சத்து - வாழை இலைகளில் பாலிபினால்கள், வைட்டமின்கள் ஏ மற்றும் சி உள்ளிட்ட பல அத்தியாவசிய ஊட்டச்சத்துக்கள் உள்ளன. உணவு பரிமாறப்படும்போது, இந்த ஊட்டச்சத்துக்கள் உணவிற்கு மாற்றப்படும். அந்த எணவை நாம் சாப்பிடும் போது அந்த சத்துக்கள் நம் உடலை வந்தடையும்.
செரிமானத்தை மேம்படுத்துகிறது - வாழை இலையில் உணவு உண்பது செரிமானத்தை மேம்படுத்துகிறது.
வாழை இலைகளில் இயற்கையான நொதிகள் மற்றும் நார்ச்சத்து உள்ளது. அவை உணவை ஜீரணிக்க மிகவும் உதவியாக இருக்கும். இது அஜீரணம், மலச்சிக்கல் மற்றும் வாயு போன்ற பிரச்சனைகளைப் போக்க உதவுகிறது.

பாக்டீரியா எதிர்ப்பு பண்புகள் - வாழை இலைகளில் பாக்டீரியாக்களின் வளர்ச்சியைத் தடுக்கும் பண்புகள் உள்ளன. எனவே, அவற்றில் உணவை உண்பது உணவு மூலம் பரவும் நோய்களின் அபாயத்தைக் குறைக்கிறது.
இலை மேற்பரப்பில் உள்ள கூறுகள் பாக்டீரியாக்கள் வளர்வதைத் தடுக்கின்றன. இதனால் உணவை சுத்தமாகவும் பாதுகாப்பாகவும் வைத்திருக்கின்றன.
வலுவான நோய் எதிர்ப்பு சக்தி - வாழை இலைகளில் உள்ள ஆக்ஸிஜனேற்றிகள் மற்றும் பாலிபினால்கள் உடலின் நோய் எதிர்ப்பு சக்தியை வலுப்படுத்த உதவுகின்றன.
இந்த சேர்மங்கள் உடலை தொற்றுநோயிலிருந்து பாதுகாக்கின்றன. வாழை இலைகளின் பாக்டீரியா எதிர்ப்பு பண்புகள் உணவில் உள்ள தீங்கு விளைவிக்கும் பாக்டீரியாக்களைக் குறைத்து, நல்ல ஆரோக்கியத்திற்கு வழிவகுக்கும்.
ரசாயனம் இல்லாதது - பிளாஸ்டிக் அல்லது வேறு பாத்திரங்களைப் போலல்லாமல், வாழை இலைகள் முற்றிலும் இயற்கையானவை இதனால் இதில் தீங்கு விளைவிக்கும் இரசாயனங்கள் இல்லை.
எனவே வாழை இலைகளில் உணவைப் பரிமாறுவது பிளாஸ்டிக்கில் பெரும்பாலும் காணப்படும் BPA போன்ற தீங்கு விளைவிக்கும் இரசாயனங்களின் அபாயத்தை நீக்குகிறது. இது உணவின் முழுமையான பாதுகாப்பை உறுதிசெய்து, மேம்பட்ட ஆரோக்கியத்திற்கு பங்களிக்கும்.
| சுவாரஸ்யமான செய்திகளை நொடிப் பொழுதில் தெரிந்து கொள்ள மனிதன் WHATSAPP CHANNEL இல் இணையுங்கள் FOLLOW NOW |